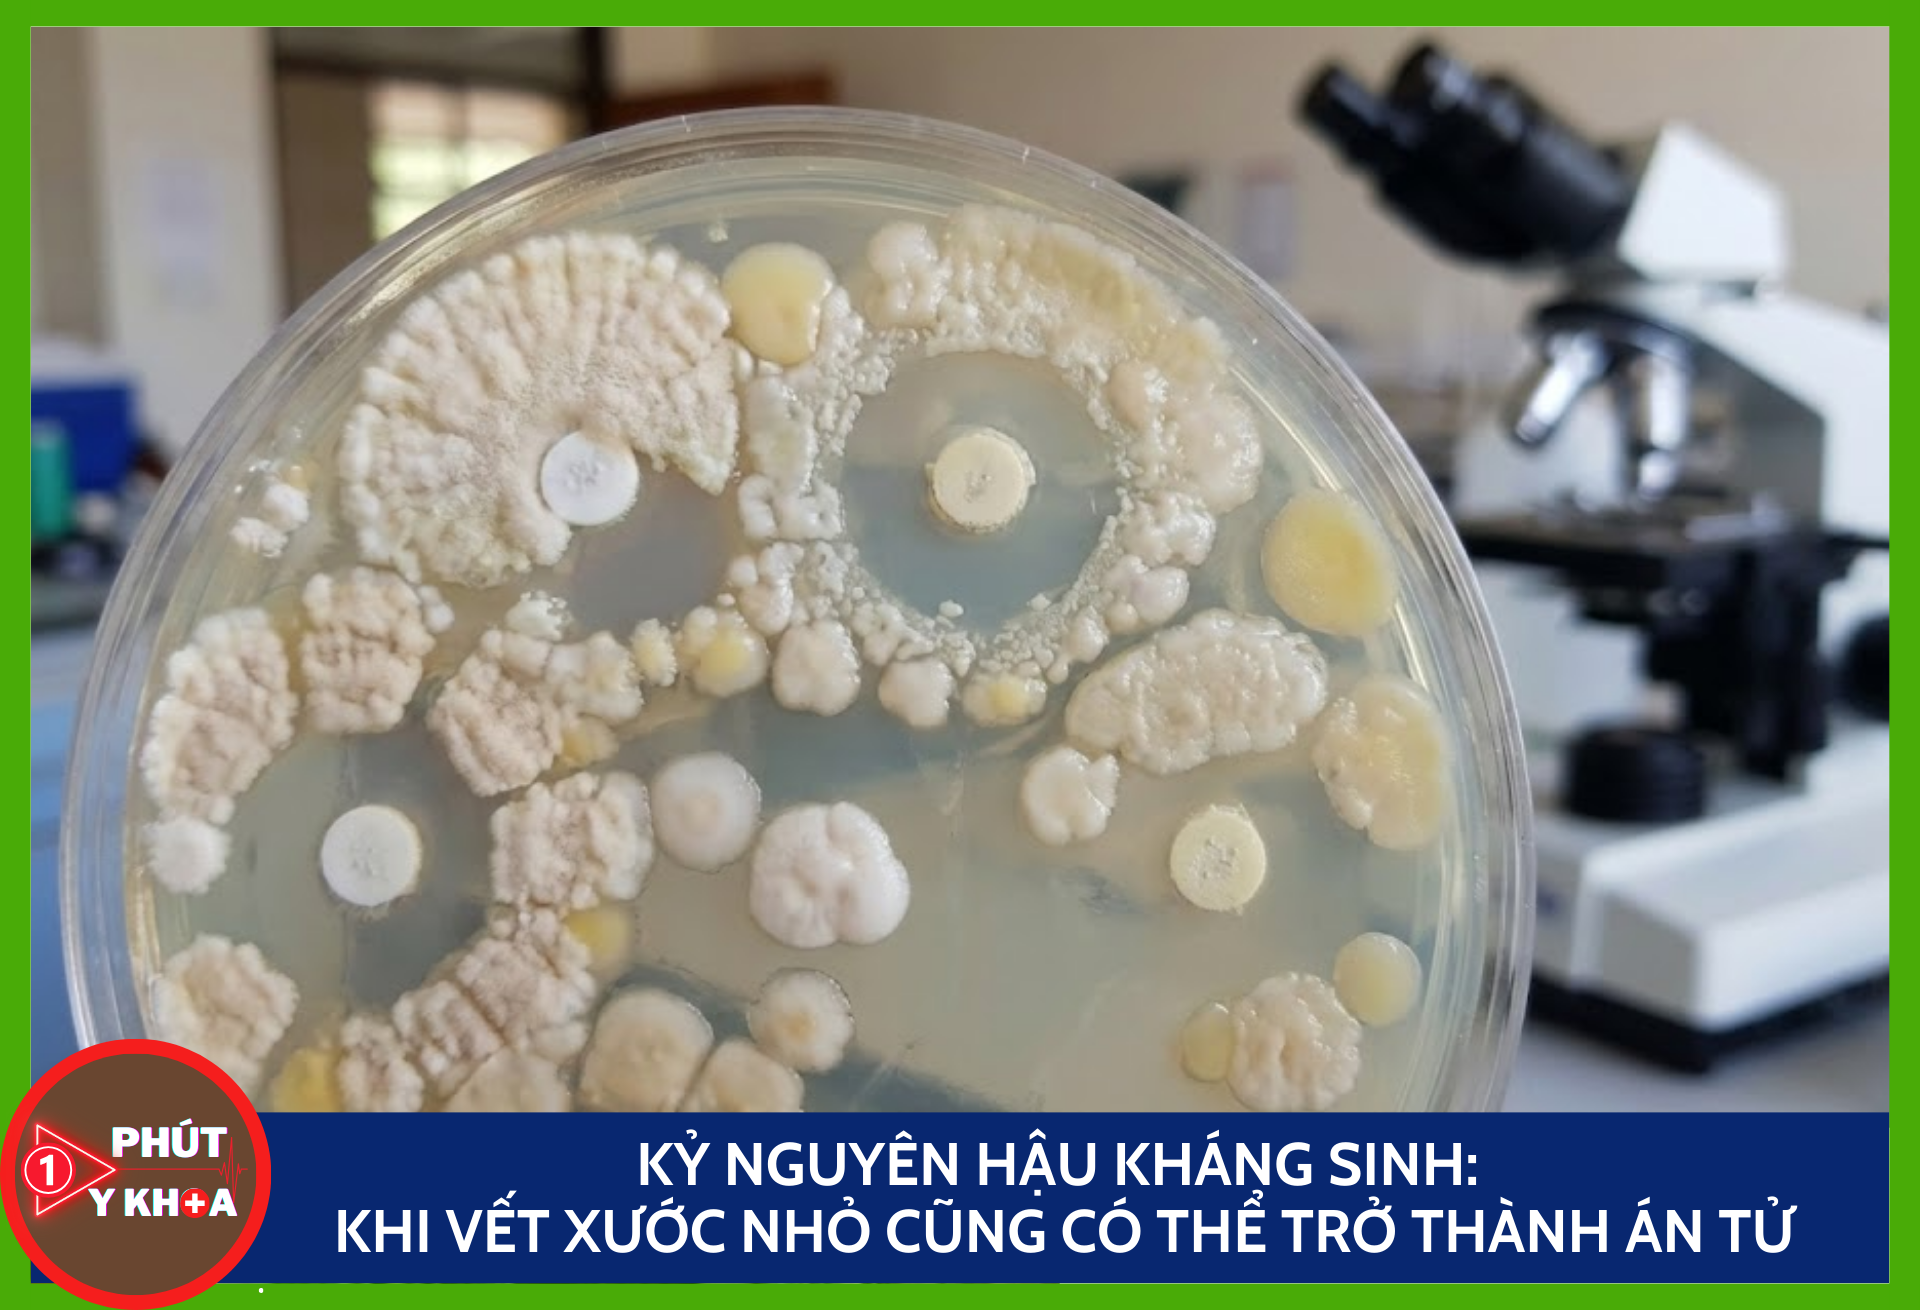
Kỷ nguyên hậu kháng sinh: Khi vết xước nhỏ cũng có thể trở thành án tử Anh bia mau 1

Kỷ nguyên hậu kháng sinh: Khi vết xước nhỏ cũng có thể trở thành án tử
Tác giả: Đinh Quang Nhật Ngày: 13/12/2025
1. Mở đầu: Lời tiên tri của cha đẻ thuốc kháng sinh
Năm 1945, khi nhận giải Nobel Y sinh học cho việc tìm ra Penicillin – loại thuốc kháng sinh đầu tiên cứu sống hàng triệu người, Alexander Fleming đã để lại một lời cảnh báo lạnh người: “Sẽ đến lúc vi khuẩn trở nên kháng thuốc nếu chúng ta sử dụng kháng sinh không đúng cách” [1].
Hơn 80 năm sau, lời tiên tri đó đang trở thành hiện thực tàn khốc. Chúng ta đang đứng trước ngưỡng cửa của “kỷ nguyên hậu kháng sinh” (post-antibiotic era). Đây là thời kỳ mà những loại thuốc từng được coi là thần dược trở nên vô dụng, và những bệnh nhiễm trùng thông thường hay những chấn thương nhỏ nhất cũng có thể cướp đi sinh mạng con người một lần nữa [2].
2. Cơ chế sinh học: Cuộc đua tiến hóa không cân sức
Kháng kháng sinh (antimicrobial resistance – AMR) không phải là hiện tượng kháng sinh bị “lờn” như cách gọi dân gian. Thực chất, đó là sự tiến hóa sinh tồn của vi khuẩn.
2.1. Chọn lọc tự nhiên và đột biến
Vi khuẩn là những sinh vật có khả năng thích nghi siêu việt. Khi chúng ta đưa kháng sinh vào cơ thể, thuốc sẽ tiêu diệt các vi khuẩn yếu. Tuy nhiên, nếu liều lượng không đủ hoặc dùng sai cách, những vi khuẩn mang gen đột biến ngẫu nhiên giúp chúng sống sót sẽ tồn tại. Chúng sinh sôi nảy nở nhanh chóng và tạo ra một thế hệ “siêu vi khuẩn” (superbugs) miễn nhiễm hoàn toàn với loại thuốc đó [3].
2.2. Sự chia sẻ vũ khí sinh học
Đáng sợ hơn, vi khuẩn có khả năng chuyển giao gen kháng thuốc cho nhau thông qua cơ chế “chuyển gen ngang” (horizontal gene transfer). Một con vi khuẩn kháng thuốc có thể truyền “bí kíp” sinh tồn của nó cho các con vi khuẩn khác, thậm chí khác loài, thông qua các đoạn DNA nhỏ gọi là plasmid. Điều này khiến tốc độ lan truyền tính kháng thuốc nhanh hơn gấp bội so với tốc độ nghiên cứu thuốc mới của con người.
3. Nguyên nhân: Lỗi lầm từ sự chủ quan của con người
Sự trỗi dậy của siêu vi khuẩn không phải là thảm họa tự nhiên, mà là thảm họa do con người tạo ra.
3.1. Lạm dụng trong y tế cộng đồng
Đây là nguyên nhân phổ biến nhất. Theo Trung tâm Kiểm soát và Phòng ngừa Dịch bệnh Hoa Kỳ (CDC), khoảng 30% toa thuốc kháng sinh được kê tại các phòng khám ngoại trú là không cần thiết [4]. Chúng ta thường có thói quen dùng kháng sinh để điều trị cảm lạnh, cúm mùa hoặc đau họng do virus – những tác nhân mà kháng sinh hoàn toàn vô hiệu. Việc uống kháng sinh khi bị nhiễm virus không những không chữa được bệnh mà còn tiêu diệt hệ vi khuẩn có lợi, tạo “sân chơi” cho vi khuẩn kháng thuốc phát triển.
3.2. Thảm họa từ chăn nuôi công nghiệp
Một lượng khổng lồ kháng sinh trên thế giới không được dùng cho người, mà được trộn vào thức ăn chăn nuôi để kích thích tăng trưởng và phòng bệnh cho gia súc, gia cầm. Theo tạp chí Science, vi khuẩn kháng thuốc hình thành trong các trang trại này sẽ theo nguồn nước, thực phẩm và phân bón xâm nhập vào chuỗi thức ăn của con người, tạo ra các ổ dịch kháng thuốc trong cộng đồng [5].
4. Viễn cảnh tương lai: Một nền y học không có lá chắn
Nếu không hành động ngay lập tức, thế giới sẽ ra sao? Báo cáo mang tính bước ngoặt của chuyên gia kinh tế Jim O’Neill (Anh Quốc) dự báo rằng đến năm 2050, kháng kháng sinh có thể giết chết 10 triệu người mỗi năm – nhiều hơn cả số người chết vì ung thư hiện nay [6].
Trong kỷ nguyên hậu kháng sinh, nền y học hiện đại sẽ sụp đổ:
-
Phẫu thuật trở nên quá rủi ro: Các ca mổ ruột thừa, thay khớp háng hay mổ lấy thai sẽ trở thành canh bạc sinh tử vì nguy cơ nhiễm trùng vết mổ không thể kiểm soát.
-
Hóa trị ung thư bị vô hiệu hóa: Bệnh nhân ung thư thường bị suy giảm miễn dịch và phụ thuộc hoàn toàn vào kháng sinh để chống nhiễm trùng. Nếu thuốc mất tác dụng, họ sẽ chết vì nhiễm trùng trước khi chết vì ung thư.
5. Giải pháp: Trách nhiệm không của riêng ai
Cuộc chiến này chưa kết thúc, nhưng thời gian không còn nhiều. Để bảo vệ “tấm khiên” cuối cùng của nhân loại, chúng ta cần tuân thủ nghiêm ngặt các nguyên tắc sau:
5.1. Nguyên tắc 4 đúng
Chỉ sử dụng kháng sinh khi có chỉ định của bác sĩ. Tuân thủ: Đúng thuốc, đúng liều, đúng đường dùng và đúng thời gian.
5.2. Tuyệt đối không bỏ dở liệu trình
Ngay cả khi cảm thấy khỏe hơn sau 2-3 ngày uống thuốc, bạn bắt buộc phải uống hết liều được kê. Việc dừng thuốc giữa chừng sẽ để lại những con vi khuẩn “ngắc ngoải” nhưng chưa chết hẳn. Chúng sẽ hồi phục, đột biến và quay lại tấn công mạnh mẽ hơn.
5.3. Phòng bệnh hơn chữa bệnh
Tiêm vắc-xin đầy đủ, rửa tay thường xuyên và ăn chín uống sôi là những biện pháp đơn giản nhất để giảm thiểu nguy cơ nhiễm khuẩn, từ đó giảm nhu cầu phải sử dụng kháng sinh.
6. Kết luận
Kháng sinh là một tài sản quý giá của nhân loại, không phải là một món hàng tiêu dùng thông thường. Mỗi lần bạn tự ý mua một vỉ kháng sinh để trị cơn đau họng thông thường, bạn đang góp phần đẩy nhân loại nhanh hơn đến bờ vực của kỷ nguyên hậu kháng sinh. Quyết định nằm ở chính hành động của bạn ngày hôm nay.
Tài liệu tham khảo
-
Fleming, A. (1945). Penicillin. Nobel Lecture, 11.
-
Ventola, C. L. (2015). The antibiotic resistance crisis: part 1: causes and threats. Pharmacy and Therapeutics, 40(4), 277.
-
World Health Organization. (2021). Antimicrobial resistance. WHO Fact Sheets.
-
Centers for Disease Control and Prevention (CDC). (2019). Antibiotic Resistance Threats in the United States, 2019. US Department of Health and Human Services.
-
Van Boeckel, T. P., Brower, C., Gilbert, M., Grenfell, B. T., Levin, S. A., Robinson, T. P., … & Laxminarayan, R. (2015). Global trends in antimicrobial use in food animals. Proceedings of the National Academy of Sciences, 112(18), 5649-5654.
-
O’Neill, J. (2016). Tackling drug-resistant infections globally: final report and recommendations. Review on Antimicrobial Resistance.
Y khoa Diễn đàn Y khoa, y tế sức khoẻ, kiến thức lâm sàng, chẩn đoán và điều trị, phác đồ, diễn đàn y khoa, hệ sinh thái y khoa online, mới nhất và đáng tin cậy.
